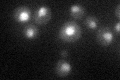
YHR165C
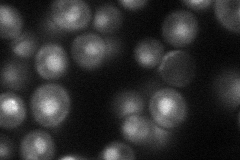
YHR165C
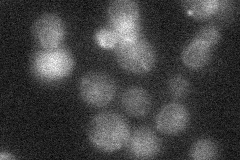
YHR165C
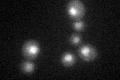
YHR165C
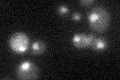
YHR165C

View description
Component of the U4/U6-U5 snRNP complex, involved in the second catalytic step of splicing; mutations of human Prp8 cause retinitis pigmentosa
Localization:
Intensity:
Fold change:
Significance:
-
C’ GFP library in SD
nucleus27.18 -
N' NOP1pr-GFP in SD
nucleus43.513 -
N' TEF2pr-mCherry in SD

nucleus12.2797 -
N' NATIVEpr-GFP in SD
ambiguous20.0236 -
N' TEF2pr-VC and Cyto-VN in SD

#N/A0 -
C’ GFP library in SD+DTT
nucleus25.930.95No -
C’ GFP library in SD+H2O2

nucleus29.971.1No -
C’ GFP library in Starvation Media
nucleus22.880.84No -
C’ GFP library on the background of Pup2-DaMP

nucleus -
C’ GFP library on the background of CCT mutant

nucleus31.85111.17155No
